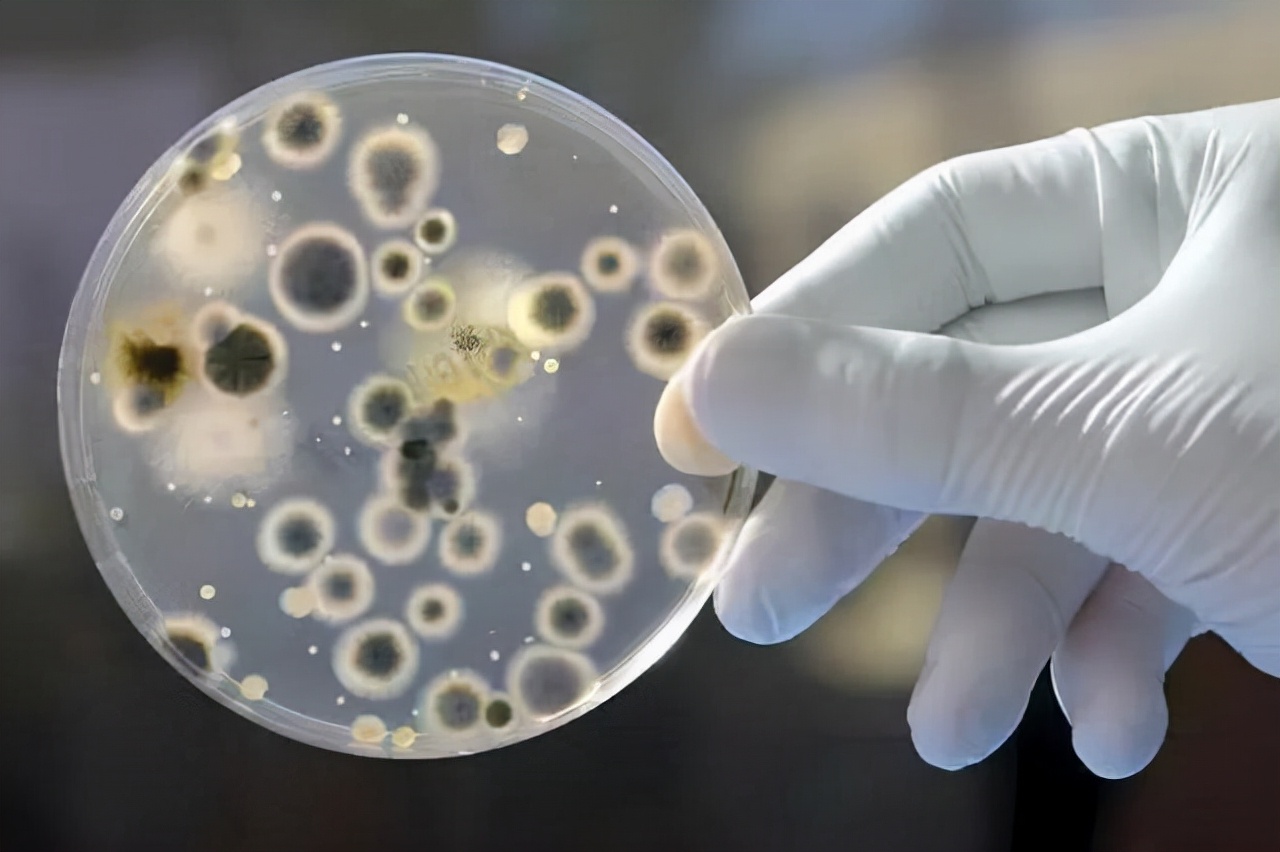
如果苍蝇灭绝对地球有什么影响,假如苍蝇灭绝了世界会变成什么样

在这个世界上,有一种非常讨人厌的生物“苍蝇”,它们不断的在人们的身上飞来飞去,发出“嗡嗡嗡”的声音,让我们难以入眠。

赶也赶不走,杀也杀不完,并且它们还会在你的身上随意的“大小便”十分的脏,有时候不禁的让人希望 :“这个世界上没有苍蝇就好了”。
没有苍蝇的世界,睡觉不会受到打扰,剩菜不会受到污染。
但是类似于“灭绝苍蝇”“世界上没有苍蝇”的想法 ,只存在幻想之中就够了,即使能办到也不能灭绝苍蝇,因为人为灭绝生物,会带来十分严重的后果。
食物链
在生物学中,我们 将必须以其他生物为食物的这种由生物联结起来的链锁关系,称为“食物链” ,如果其中的一环受到影响,那么整个食物链都会因此而崩盘。

在上个世纪五十年代时,人们将麻雀列为了 “四害(苍蝇、蚊子、老鼠、蟑螂)”中的一害, 它随后被蟑螂所替代。

在当时一对麻雀在一年里,可以孵出10只到40只小麻雀,这对当时那个粮食紧缺的年代,是十分致命的。
因为一只麻雀在一年里会消耗将近2公斤的粮食,这么多的麻雀就等于是在人类的嘴里面抢食物,人类自己都吃不饱,又怎么会允许它们来抢呢?
于是当地的人纷纷开启了 “灭雀之行” ,他们捅鸟窝、打碎鸟蛋、杀麻雀,导致麻雀差点在中国灭绝。
但让人意想不到的是,麻雀的数量确实少了下来,但是粮食的数量却没有增多,反而变得更少了。

这是因为没了麻雀的威胁,庄稼地里的害虫开始大量的增长,最终导致粮食歉收。
苍蝇在食物链中的地位
而消灭苍蝇也同样会有上述的危害,苍蝇虽然小,但却是食物链中的“消费者”。
苍蝇属于双翅目蝇科动物,以 双翅目学者命名的蝇类在世界上有40000多种,在我们中国分布着其中的5000多种。

我们常常见到的苍蝇,也被叫作“家蝇”它们是杂食性动物,什么都吃,但一般会以人们, 所生存环境中的“腐败物质”,或是“动物的排泄物”为食,它们属于“腐生性物种”。

可千万不要觉得它们恶心 ,它们的存在可以帮助我们改善自然界的环境,如果没有它们的存在,这些腐败物质、垃圾、排泄物,将会分解得很慢,其中的细菌会不断地增长,对周围的环境和人类的健康产生影响。
俗话说 “一人吃饱,全家不饿” ,它们不只会吃, 还会将这些物质,进行分化,逐渐将它们变成大地的肥料,滋养植物的生长。

这就让其他的草食性昆虫,有了食物,并且它们自身也十分的“伟大”,在分化了这些“垃圾”之后,它们会变成其他生物眼里的“营养品”。
因此在食物链中,苍蝇有着谁都无法替代的地位,如果它消失了,那么将会有很多的动物因为缺乏食物而灭绝。
苍蝇变宝
不止是这样,苍蝇在我们的生活当中,也起到了很多有利的用处。
它可以作为食品供人食用,在它的体内含有丰富的蛋白质和人类所需要的维生素,还可以作为饲料给动物食用,这一点是较为广泛的。

并且苍蝇的生命历程非常的短暂,几乎可以以天来计算,它的幼虫期只有3到6天,从卵发育到成虫只需要短短的7到14天。
在成虫一两天后,它们就又可以进行繁殖,只需要几天就可以产出一堆一堆的卵,因此它们的制作成本十分的便宜,质量还高。

其二就是“科研研究” ,腐蚀性的苍蝇在进食的时候,同样会吃到一些会危害到自己生命的细菌,因此它们在进食的时候会“边吃边吐”甚至还会在此时“排泄”,在食物充足的情况下,它们每分钟会排泄3到5次。
这是因为它们处理食物的速度非常的快,几乎7到11秒,就可以将食物中的营养吸收完,将废物排掉。

即使是繁殖性再强的细菌都无法催害它们的身体,它们的体内会不定期的分泌出“抗菌活性蛋白”。
当遇到细菌时,它的免疫系统会产生 “ BF64”和“BD2 ” 这两种蛋白,它们在和细菌接触时, 会进行“同归于尽”。

根据研究,这两种蛋白的杀菌能力是远在青霉素之上的, 如果在未来可以提取到苍蝇体内的这两种蛋白,对我们医学的影响非常之大,会治愈很多现在无法解决的疑难杂症。
所以虽然苍蝇非常的讨厌,但是它们对我们的生活却有着不可忽略的贡献,这些贡献,让我们没办法离开它。
苍蝇对人类的危害
不过话又说回来了,苍蝇作为四害中的一类,当然不是越多越好,它们也会对我们的健康造成一定的危害。
苍蝇所生存的环境,让它们很容易携带上病原,它们能够传播50多种疾病,比如禽流感、新城疫等等,这些疾病对牲畜的危害非常的大。

而由于它们的杂食性,它们还会在人类所吃的食物上停留,如果不小心吃了,也很容易感染疾病。
并且不止如此,它们还会引起家畜的暴怒,让它们精神处于不安的状态,这会让家畜之间进行斗争,导致其肉食性降低。

预防措施
对于这样 “有百害而无一利” 的生物,不能将其灭绝,那我们就只能对它们进行一定的预防措施,来降低它们对我们生活的影响。
首先是 “物理灭蝇” ,我们要定期的进行大扫除,不要让垃圾堆积起来,尤其是“餐厨垃圾”,因为堆积的餐厨垃圾中含有苍蝇们最喜欢的营养物质,是苍蝇最喜欢生存的环境。

其次是 “化学灭蝇” ,我们可以用一些杀虫剂,喷洒在垃圾、厕所这些地方,这可以将苍蝇“扼杀于摇篮之中”。
结语
无论是什么生物,在大自然中都有着属于它的地位,即使是被人们称为“四害”的生物也不例外。
这或许就是大自然的魅力,它养育了所有的生物,赋予了它们不同的任务,让彼此紧紧地联系在一起。
因此我们不应该人为地去干扰、灭绝食物链中的任何一环,它所造成的后果我们根本无法承担。
